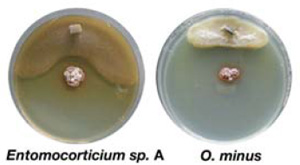
Так проверяли влияние актинобактерий (красной разновидности) на рост грибов: «полезного» для жуков Entomocorticium sp. A и «вредного» Ophiostoma minus. В центр чашки Петри сажали актинобактерий, а на краю сеяли гриб. Видно, что Entomocorticium растет лучше и может приблизиться к актинобактериям на меньшее расстояние, чем O. minus. Фото из дополнительных материалов к обсуждаемой статье в Science

Жуки-лубоеды Dendroctonus frontalis, опасные вредители сосновых лесов, разводят в ходах под корой сосен съедобные грибы, которыми питаются их личинки. Оказалось, что жуки защищают свои грибные плантации от сорняков при помощи симбиотических бактерий, выделяющих неизвестный ранее антибиотик. До сих пор столь сложный «сельскохозяйственный» симбиоз, состоящий из животного, культивируемого им гриба и бактерии, производящей пестицид, был известен только у муравьев-листорезов.
Жук-лубоед Dendroctonus frontalis, которого в США называют «южным сосновым жуком» (southern pine beetle), наносит большой урон сосновым лесам на юго-востоке США. Неудивительно, что ученые стараются как можно лучше изучить его биологию, чтобы придумать, как с ним бороться.
Эти усилия привели к важному открытию, которое, впрочем, имеет отношение скорее к поиску новых антибиотиков и изучению симбиотических систем и агрикультуры у животных, чем к насущным проблемам американского лесного хозяйства.

Лубоед D. frontalis прогрызает под корой сосны извилистые ходы и засевает их грибом Entomocorticium, который служит пищей личинкам жука. Взрослые жуки бережно хранят небольшое количество гиф и спор гриба — посевной материал для плантаций — в особых углублениях (микангиях) на нижней стороне груди.
Сельскохозяйственной деятельности жука мешает другой гриб — Ophiostoma, который не годится в пищу личинкам и играет на жучиных плантациях роль агрессивного сорняка. Гриб-сорняк действует не в одиночку, у него тоже есть покровители-симбионты — маленькие клещи, которые перебираются с одного дерева на другое, прицепившись к жуку-лубоеду. Клещи питаются грибом Ophiostoma, а в качестве «платы за услуги» помогают грибу распространяться по лесам и попадать в галереи жуков-грибоводов.
У клещей для переноса грибов тоже есть специальные углубления на теле, подобные микангиям жуков. В этой сложной симбиотической системе есть еще один участник, гриб Ceratocystiopsis, который состоит во взаимовыгодных отношениях с клещами, но может также служить пищей личинкам жука.

Изучая содержимое микангиев и засеянных грибами ходов под сканирующим электронным микроскопом, исследователи обнаружили там, помимо перечисленных трех видов грибов, тонкие нити актинобактерий. Актинобактерии — своеобразная и очень древняя группа прокариот, представители которой образуют ветвящиеся нитевидные многоклеточные структуры, похожие на грибницу. Неудивительно, что до недавних пор актинобактерий считали грибами и называли «актиномицетами». Сходство с грибами у этих бактерий настолько велико, что они, подобно настоящим грибам, способны образовывать симбиотические комплексы с одноклеточными водорослями. Эти комплексы называют актинолишайниками (см.: Г. М. Зенова. Лишайники — симбиотические организмы, состоящие из гриба и водоросли).
Актинобактерии — большие мастера по производству всевозможных антибиотиков. Известно, что муравьи-листорезы, выращивающие съедобные грибы на грядках из пережеванных листьев, защищают свои огороды от паразитов при помощи антибиотиков, выделяемых симбиотическими актинобактериями (см.: Муравьи-листорезы приручили бактерий для борьбы с вредителем, «Элементы», 25.01.2006).
Поэтому, обнаружив актинобактерий в микангиях и «грибных галереях» жуков-лубоедов, ученые сразу предположили, что и в данном случае, как у муравьев-листорезов, может иметь место симбиоз между жуками и актинобактериями, производящими антибиотик.
Актинобактерий изолировали и стали выращивать на питательной среде. Оказалось, что жуки носят в своих микангиях две разновидности актинобактерий — белую и красную. Белая разновидность, по-видимому, не приносит жукам пользы, тогда как красная эффективно подавляет рост гриба-сорняка Ophiostoma. Правда, культивируемый жуками гриб Entomocorticium тоже растет несколько хуже в присутствии этих актинобактерий, чем без них, но гриб Ophiostoma страдает гораздо сильнее.
Таким образом, актинобактерии действительно помогают жукам бороться за высокие урожаи.
Ученые не остановились на достигнутом и выделили из красных актинобактерий действующее вещество, которое оказалось неизвестным ранее антибиотиком. Вещество назвали «микангимицином».
Выяснилось, что микангимицин производится в больших количествах красными актинобактериями, а белые не выделяют его совсем. Чистый микангимицин эффективно подавляет рост обоих грибов — и «полезного» Entomocorticium sp. A, и «вредного» Ophiostoma minus, однако для этого требуются разные концентрации антибиотика. Чтобы затормозить рост гриба-сорняка, достаточно очень низких концентраций микангимицина. Чтобы в такой же степени замедлить рост гриба Entomocorticium, концентрация должна быть повышена в 20 раз.

Открытие показало, что сложные «сельскохозяйственные» симбиотические системы, включающие, помимо культивируемого гриба, еще и бактерию — защитника от сорняков или паразитов, не являются уникальной особенностью муравьев-листорезов. Не исключено, что и грибная агрикультура, и защитные симбиотические актинобактерии будут найдены и у других насекомых, жизнь которых связана со средами, благоприятными для роста грибов, — с живыми и мертвыми деревьями, опавшими листьями и т. п. Авторы отмечают, что фармакологам тоже следует обратить внимание на подобные симбиотические системы как на потенциальный источник новых антибиотиков.
Источник: Jarrod J. Scott, Dong-Chan Oh, M. Cetin Yuceer, Kier D. Klepzig, Jon Clardy, Cameron R. Currie. Bacterial Protection of Beetle-Fungus Mutualism // Science. 2008. V. 322. P. 63.



